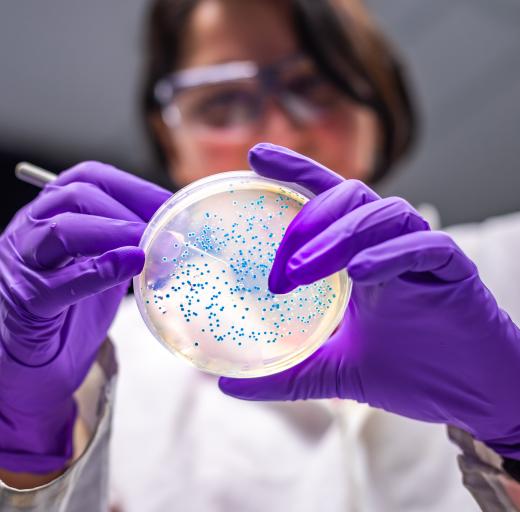

Langer gevoelig voor antibiotica – tussentijdse resultaten
‘Het zou een grote winst zijn als mensen met een longziekte zich beter voelen en minder longaanvallen hebben.’ Dat zegt farmacoloog Coen van Hasselt. Met een aangepast behandelschema waardoor bacteriën in de longen langer gevoelig zijn voor antibiotica, hoopt hij dat langdurige longinfecties in de toekomst beter te behandelen zijn.
In 2022 kreeg prof.dr. Coen van Hasselt voor dit onderzoek van Longfonds een subsidie van 200.000 euro. Inmiddels zijn de eerste resultaten bekend. We spraken hem hierover.
Oorzaak en gevolgen van een longontsteking
Een longontsteking wordt veroorzaakt door een ziekmakende bacterie of een virus. Er ontstaat een heftige ontstekingsreactie in de long waardoor je erg ziek kunt worden. ‘Juist mensen met longziekten of andere aandoening die het afweersysteem beïnvloedt, zijn vatbaar voor het krijgen van een longontsteking’ zegt Coen van Hasselt. ‘Een ernstige longontsteking veroorzaakt door een bacterie, wordt vaak behandeld met antibiotica. Bij chronische longontstekingen, zoals bij mensen met bronchiëctasieën, zorgt de vaak permanente aanwezigheid van bacteriële ziekteverwekkers - en de ontstekingsreactie die daarbij hoort - voor schade aan het longweefsel.’

'Het voordeel van deze behandelingen zou kunnen zijn dat resistentie minder snel ontstaat. En misschien ook dat er minder van het antibioticum nodig is waardoor de kans op bijwerkingen kleiner is.'
De voor- en nadelen van antibiotica
Antibiotica zijn medicijnen die bacteriën kunnen doden. Ze zijn belangrijk bij de behandeling van longontstekingen. Ze zijn niet werkzaam tegen longontstekingen veroorzaakt door een virus, zoals bijvoorbeeld Influenza. Coen van Hasselt: ‘Veel antibiotica hebben ook invloed op “goede” bacteriën in ons lichaam, zoals in de darm. Dat is niet wenselijk. Maar bij een ernstige longontsteking is het behandelen van de infectie uiteindelijk toch het belangrijkst. Sommige antibiotica kunnen tot ernstige bijwerkingen leiden en soms alleen via een infuus in het ziekenhuis worden toegediend. Dit kan erg belastend zijn. Verder zien we steeds vaker resistentie ontstaan. Dan zijn de bacteriën ongevoelig geworden voor de antibiotica waardoor er steeds minder opties overblijven om ernstige infecties goed te behandelen.’
Resistentie voorkomen en minder bijwerkingen
Het onderzoek van Coen van Hasselt richt zich op het ontwikkelen van combinatie-behandelingen met meerdere antibiotica. ‘Het voordeel van deze behandelingen zou kunnen zijn dat resistentie minder snel ontstaat. En misschien ook dat er minder van het antibioticum nodig is waardoor de kans op bijwerkingen kleiner is. Nu is hierover nog weinig bekend. In ons onderzoek richten we ons op de behandeling van één veelvoorkomende bacterie die vaak chronische longontstekingen veroorzaakt: de Pseudomonas aeruginosa.’
Resultaten tot nu toe
‘In de eerste fase van dit onderzoek hebben we heel breed gekeken welke combinaties van antibiotica wenselijke effecten opleveren’ legt Coen van Hasselt uit. ‘We hebben één specifieke, veelbelovende combinatie gevonden. Deze combinatie onderzoeken we nu verder in het laboratorium om zeker te zijn dat dit inderdaad van meerwaarde voor mensen met een longziekte is. Deze resultaten gaan we daarna, samen met wat we weten over hoe deze antibiotica zich in het menselijk lichaam gedragen, combineren in een computermodel. Daarmee kunnen we een optimale behandelstrategie ontwerpen.’
Veelbelovend onderzoek
In de loop van 2025 hopen de onderzoekers een antibiotica-combinatie te hebben gevonden die werkt. ‘Als uit andere proeven ook dezelfde resultaten komen, is de volgende fase onderzoek doen in mensen’ zegt Coen van Hasselt. Dit is goed nieuws voor mensen die regelmatig longontsteking hebben die veroorzaakt wordt door de Pseudomonas bacterie. Voor sommigen van hen zal deze nieuwe combinatie van antibiotica zorgen voor een betere behandeling van de infectie én voor minder antibioticaresistentie. ‘Deze ontwikkelde strategie willen we daarna ook op enkele andere veelvoorkomende bacteriële ziekteverwekkers (her-)gebruiken.’
Tekst: Judith Langeland
Dossier